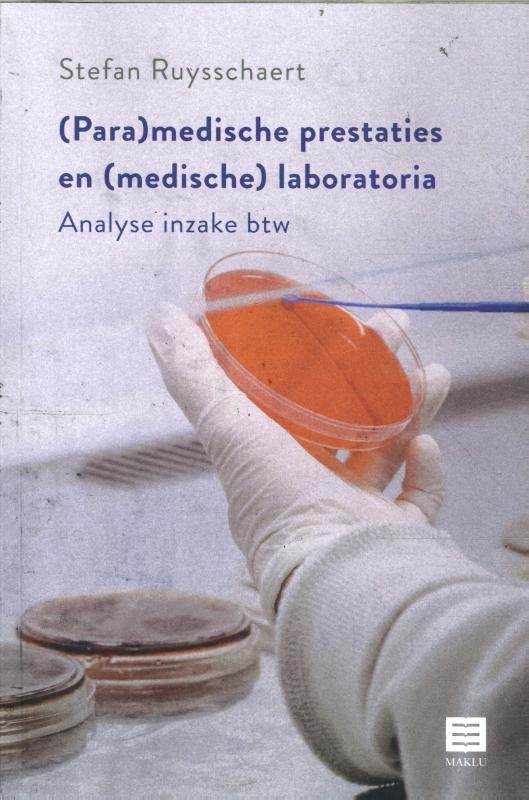
(Para)medische prestaties en (medische) laboratoria

Laden...
In het kort
Samenvatting
Het omgevingsplan is één van de belangrijkste instrumenten in de Omgevingswet en speelt een grote rol in het kader van de centrale vier verbeterdoelen van deze wet. Het omgevingsplan moet gaan bijdragen aan een samenhangende benadering van de fysieke leefomgeving en meer flexibiliteit bieden voor zowel bestuursorganen als voor burgers en bedrijven ten opzichte van het huidige bestemmingsplan. Daarbij geldt echter tevens het uitgangspunt dat het materiële beschermingsniveau en het niveau van rechtsbescherming gelijkwaardig moet blijven.
De Omgevingswet treedt in 2021 in werking. Gemeenten hebben tot dat moment om kennis te maken met het omgevingsplan en zich daar goed op voor te bereiden. Het preadvies geeft hiertoe een aanzet, door uit een juridische invalshoek de mogelijkheden en de kaders van het instrument te schetsen.
In het preadvies gaan de preadviseurs in op twee afgebakende onderwerpen: de beoogde integraliteit van het omgevingsplan en de mogelijke gevolgen voor de rechtsbescherming bij het omgevingsplan. De auteurs sluiten het preadvies af met een hoofdstuk waarin de conclusies zijn opgenomen.
In het kort
Het omgevingsplan is één van de belangrijkste instrumenten in de Omgevingswet en speelt een grote rol in het kader van de centrale vier verbeterdoelen van deze wet. Het omgevingsplan moet gaan bijdrag...
Specificaties
Auteur
F.A.G. Groothuijse
Uitgever
Stichting Instituut voor Bouwrecht
Taal
Nederlands
Aantal pagina's
160
Formaat
Paperback
Publicatiedatum
7 december 2017
ISBN
9789463150286
Wij helpen je graag!
Kom je er niet direct uit? Wij helpen je graag met al jouw vragen.
Misschien vind je deze boeken ook leuk...
Leuk om te lezen naast "Het omgevingsplan, integraal en marginaal?"